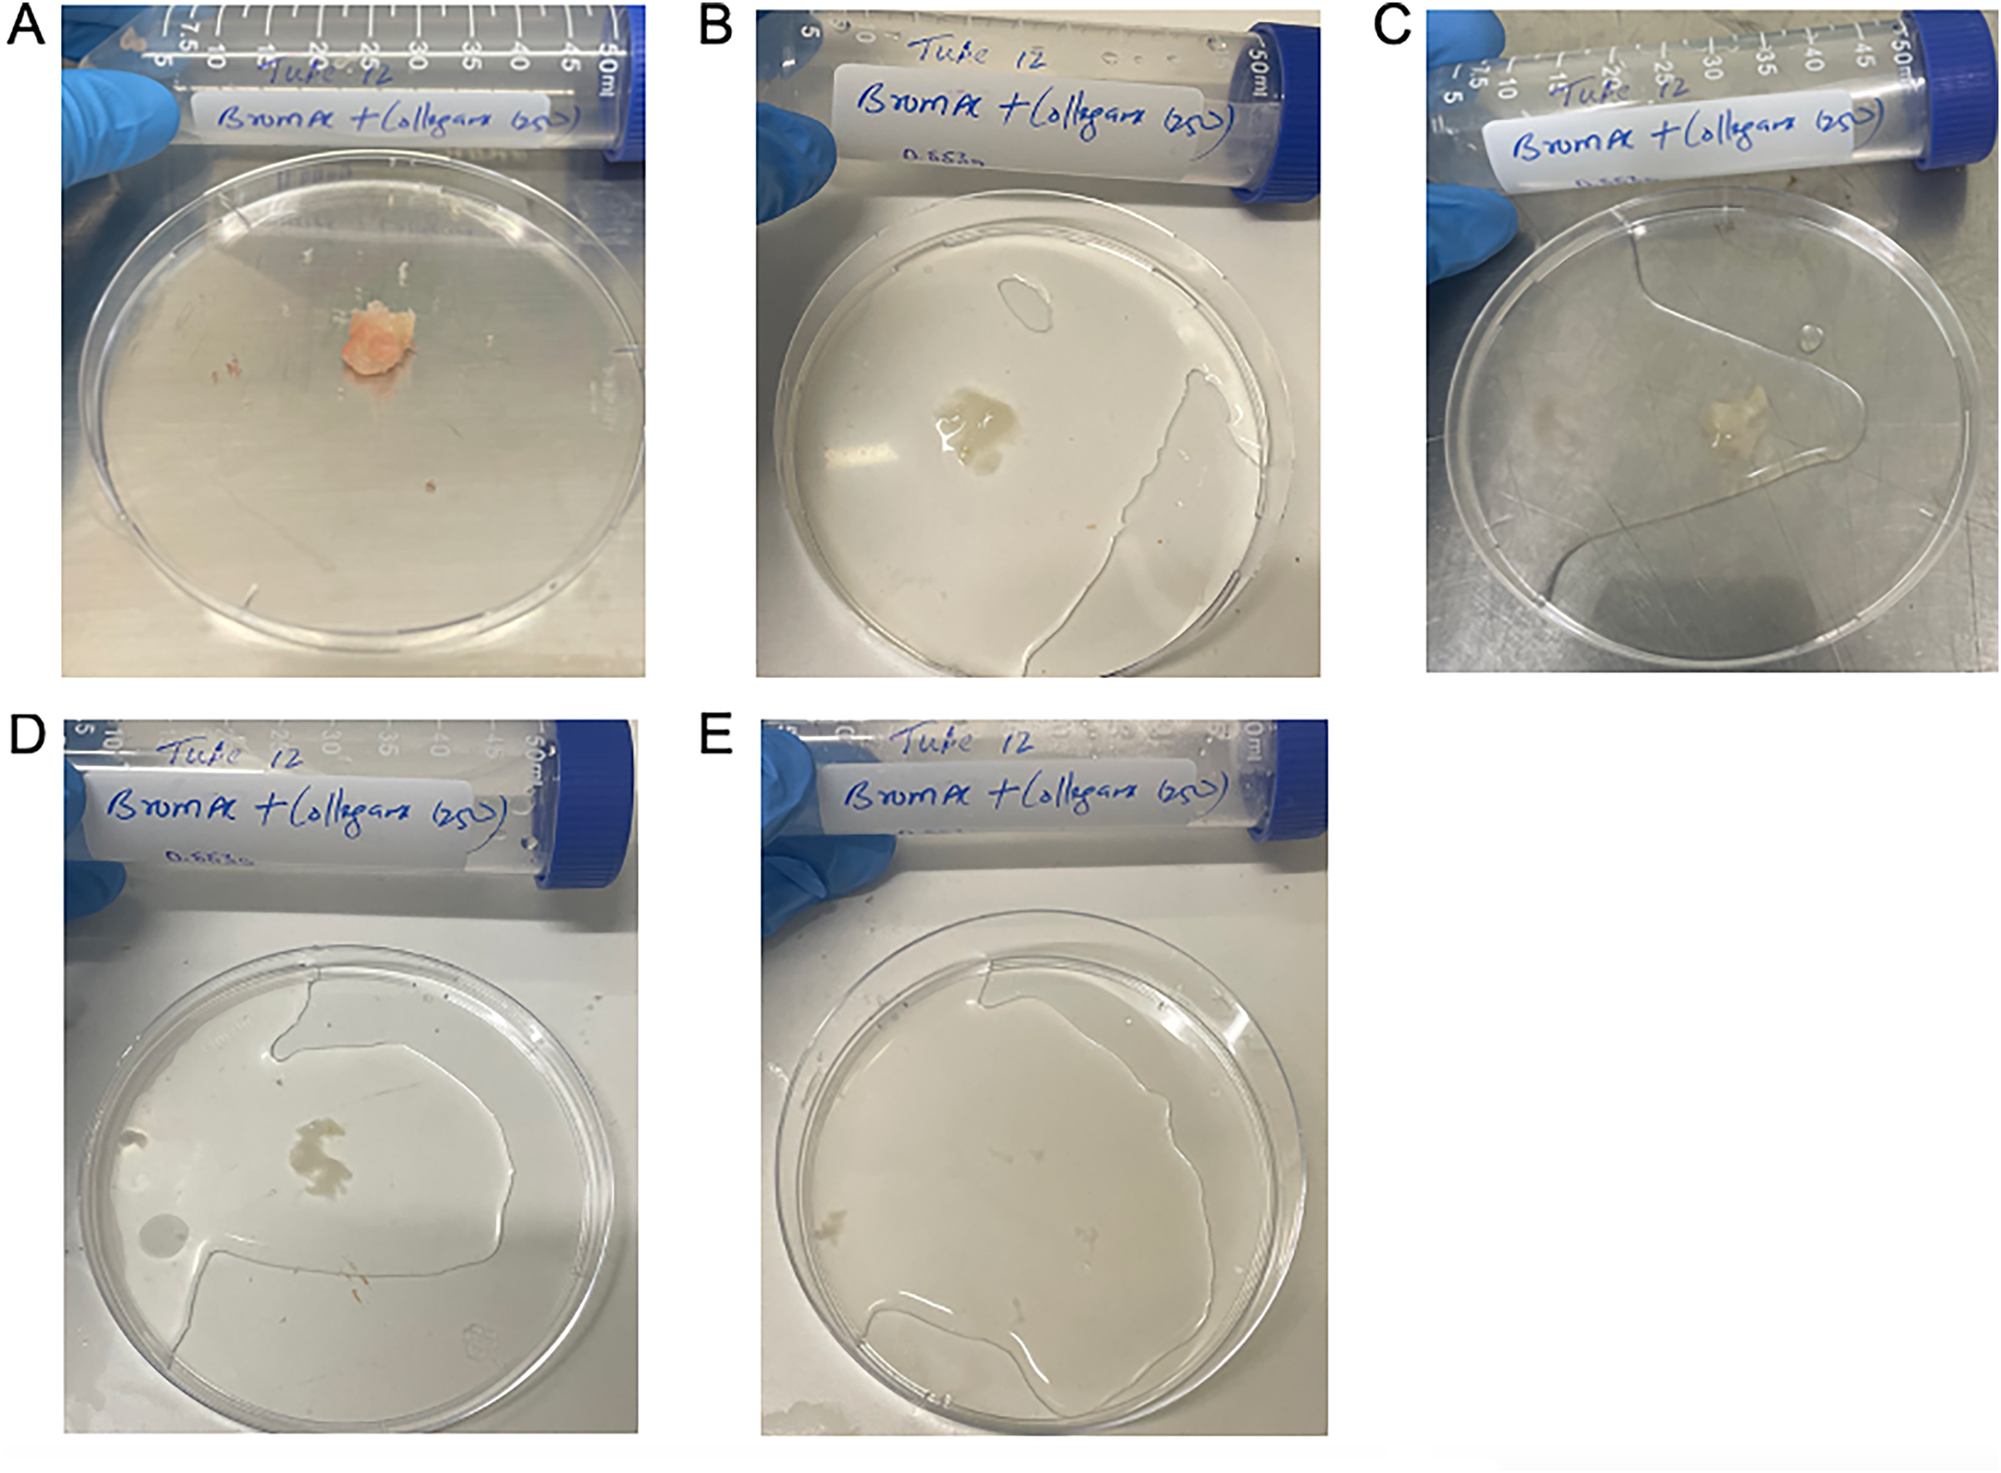
Figure 3:
Qualitative demonstration of dissolution of hard mucin when submersed in BromAc
®
+ collagenase 250 ug/mL, trial 2. A: 0 h, B: 1 h, C: 3 h, D: 5 h, E: 24 h.

Abstract
Objectives
Pseudomyxoma peritonei (PMP) is a rare peritoneal malignancy. BromAc ® is a novel therapeutic agent which has been developed to dissolve and facilitate the drainage of mucin as a palliative treatment for PMP; however, its effect is significantly reduced in patients with hard mucin. This study aimed to assess whether combining collagenase or cysteamine with BromAc ® would be more effective in dissolving hard mucin.
Methods
This preclinical human in vitro study examined the effect of adding collagenase to BromAc ® on hard mucin samples when incubated at 37 °C over 24 h. The effect of cysteamine alone and in combination with collagenase and BromAc ® was also examined as a supplementary arm of this study. Five experiments were conducted with appropriate controls. Human hard mucin samples were sliced into equal fractions using a sterile surgical scalpel, weighed and noted. The leftover solid mucin was weighed at 0, 1, 3, 5, and 24 h post-treatment.
Results
At 24 h post-treatment, all combinations with collagenase demonstrated almost 100 % dissolution of hard mucin. At 3 and 5 h post-treatment, only BromAc ® with collagenase at 250 μg/mL was found to be superior to BromAc ® alone. Combinations with cysteamine were not found to be effective.
Conclusions
This study provides promising evidence of the efficacy and synergistic effect of combining BromAc ® with collagenase to dissolve hard mucin. Further preclinical and clinical research should be undertaken to assess its safety and efficacy in the clinical setting.
Introduction
Pseudomyxoma peritonei (PMP) is a rare peritoneal malignancy affecting approximately two in one million people, which typically originates from mucinous appendiceal tumours [1], 2]. It results in the progressive accumulation of mucinous material and tumour within the abdomen and pelvis [1], 2]. Untreated, the build-up of mucin leads to increasing abdominal distension as well as compression of the gastrointestinal tract, causing malnourishment and bowel obstructions [1], 2]. Mucin produced by PMP can be categorised as soft, semi-hard and hard [1]. This is based on various physical and chemical differences including the amount of cellular content, thiol distribution, hydration status and content of glucose, proteins and lipids [1]. Soft mucin is made up of 100 % glycoprotein, denser and has a higher concentration of sulfhydryl and disulphide bonds as well as higher amounts of protein, glucose and lipids [1]. Harder mucins have increasing amounts of cellular material and are accordingly less dense with lesser amounts of proteins, glucose and lipids and less sulfhydryl and disulphide bonds [1].
The current standard of curative treatment for PMP is cytoreductive surgery (CRS) with hyperthermic intraperitoneal chemotherapy (HIPEC); however, many patients require further operations with complication rates and technical difficulty increasing with each subsequent surgery [2], [3], [4]. For patients who are not operative candidates, limited treatment options exist as systemic chemotherapy is not typically effective in PMP [2], 3]. In this subset of patients, percutaneous drainage of the mucin to reduce the burden of disease can be considered [2].
BromAc ® is a novel mucolytic therapy developed to facilitate percutaneous drainage of mucin [1], 5], 6]. A combination of bromelain and N-acetylcysteine, BromAc ® , breaks down the peptide and cysteine-disulphide bonds of the glycoprotein within mucin [1], 5], 6]. N-acetylcysteine further contributes to regenerating the active component of bromelain to potentiate its effects [6]. Preliminary trials have demonstrated BromAc ® to be a safe therapy; however, its effectiveness varies depending on the hardness of the mucin [1], 2], 5]. In vitro studies have demonstrated that while BromAc ® is 100 % effective in dissolving soft mucin, its effectiveness in semi-hard and hard mucin decreases to 60 and 40 %, respectively [1].
Thus, while BromAc ® is considered to be effective as a palliative treatment of PMP with soft mucin, there is a clinical need for the development of a combination therapy that is similarly effective in treating PMP that produces harder types of mucin.
A key reason for chemoresistance in harder tumours is due to the tumour stroma preventing the penetration of the drug [7]. The extracellular matrix of the tumour stroma is composed largely of collagen as well as cysteine-disulphide bonds, leading to the hypothesis that intraperitoneal administration of collagenase could therefore be effective in facilitating breakdown of the tumour stroma and enhanced penetration of intraperitoneal chemotherapy [7].
Collagenase is an enzyme that degrades collagen, a diverse family of proteins [8]. Collagen makes up about 30 % of the total protein content of the body and is the primary protein in the extracellular matrix [8]. All collagens have a common domain of three polypeptide chains [8]. Physiologically, collagenase promotes the degradation and re-synthesis of collagen fibres, which is essential for normal growth, wound healing and regeneration of tissue [8]. In the clinical setting, collagenase is a currently accepted treatment for the management of Dupuytren’s disease, Peyronie’s disease, debridement of cutaneous ulcers and burns management [8], [9], [10].
Cysteamine is an aminothiol and is a decarboxylated derivative of cysteine [11]. Cysteamine exerts a variety of actions under different conditions [11]. These include acting as an antioxidant, changing gene expression and changing enzymatic activity [11].
Given BromAc ® is 100 % effective in dissolving soft mucin that is composed solely of glycoprotein, it was postulated that the reduced effect of BromAc ® on hard mucin was due to its higher cellular content and hence more significant extracellular matrix. It was therefore hypothesised that the addition of collagenase to BromAc® would facilitate degradation of this extracellular matrix and improve the penetration of BromAc®. Similarly, given the presence of cysteine-disulphide bonds within mucin, a secondary hypothesis was formed that the combination of bromelain with cysteamine with or without the addition of collagenase may also have an enhanced effect compared to BromAc® alone [11].
Materials and methods
The study was conducted with pre-existing approval from the St George Hospital Ethics Committee (approval number 2023/ETH01237). A frozen sample of hard mucin previously collected under sterile conditions and frozen immediately at a temperature of −80 °C was thawed in a 37 °C water bath on the day of each experiment. This mucin was collected intraoperatively from a human female patient with PMP. In this study, the same sample of mucin was used for each trial.
All chemical agents were procured from Sigma Aldrich Chemicals, Sydney, Australia. A standard commercially available Type IV collagenase (product code C5138) was used. Concentrations of bromelain, NAC and BromAc ® were chosen to reflect their current clinical use. Previous studies that have assessed the intraperitoneal use of collagenase have found a dose of 37.5 units/mL to be both safe and effective in both rat and pig models [7], 12]. This has accordingly informed the concentrations of collagenase tested in this study, which is approximately equivalent to 250 μg/mL of collagenase.
Preparation of drug solutions
A total of five trials were conducted. All trials included 0.9 % saline, bromelain, NAC and collagenase as controls. The concentrations of controls were as follows:
Bromelain (600 μg/mL),
NAC (20 mg/mL),
BromAc ® [Bromelain (600 μg/mL) with NAC (20 mg/mL)],
Collagenase (62.5–500 μg/mL) (variation between trials).
Table 1 provides an overview of the solutions used for each trial. In summary, BromAc ® with varying concentrations of collagenase was assessed, as well as bromelain with collagenase and NAC with collagenase. Trials 1 and 2 additionally assessed the efficacy of combining bromelain with cysteamine as well as bromelain, cysteamine and collagenase. These two trials also had a cysteamine control included.
Test solutions and controls across trials 1–5.
| Trial | Controlsa | Test solutionsa |
|---|---|---|
| 1 | Saline Bromelainb NACb Collagenase 500 Cysteamine 14 mg/mL BromAc ®b |
BromAc
®
+ cysteamine 14 mg/mL BromAc ® + collagenase 500 BromAc ® + collagenase 250 BromAc ® + collagenase 125 |
| 2 | Saline Bromelainb NACb Cysteamine 14 mg/mL Collagenase 500 BromAc ®b |
NAC 200 mg/mL Bromelain + cysteamine 14 mg/mL Bromelain + collagenase 500 NAC + collagenase 500 BromAc ® + collagenase 500 BromAc ® + collagenase 250 BromAc ® + collagenase 125 Bromelain + cysteamine 14 mg/mL + collagenase 500 |
| 3 | Saline Bromelainb NACb NAC 200 mg/mL Collagenase 250 BromAc ®b |
Bromelain + collagenase 250 NAC + collagenase 250 BromAc ® + collagenase 250 BromAc ® + collagenase 125 BromAc ® + collagenase 62.5 BromAc ® + collagenase 31.25 |
| 4 | Saline Bromelainb NACb Collagenase 250 BromAc ®b |
Bromelain + collagenase 250 NAC + collagenase 250 BromAc ® + collagenase 250 BromAc ® + collagenase 125 BromAc ® + collagenase 62.5 BromAc ® + collagenase 31.25 |
| 5 | Saline Bromelainb NACb BromAc ®b Collagenase 250 Collagenase 125 Collagenase 62.5 |
BromAc
®
+ collagenase 250 BromAc ® + collagenase 125 BromAc ® + collagenase 62.5 Bromelain + collagenase 250 Bromelain + collagenase 125 Bromelain + collagenase 62.5 NAC + collagenase 250 NAC + collagenase 125 NAC + collagenase 62.5 |
-
aUnless otherwise specified solutions in μg/ml. bConcentrations of BromAc ® , bromelain and NAC remained standard across all trials and solutions. BromAc ® : bromelain 600 μg/ml + NAC 20 mg/ml, bromelain 600 μg/ml, NAC 20 mg/ml. NB NAC 200 mg/ml also used in trials 2 and 3 as specified above.
Preparation and testing of hard mucin
(0.5 g) was measured for each sample and added to a test tube containing 5 mL of the test solution or control. The specimens were incubated in a 37 °C water bath for 24 h.
For the first trial, specimens were weighed at 0 and 24 h. For subsequent trials, specimens were weighed at 0, 1, 3, 5 and 24 h to provide further information on the activity of each solution over the 24-h period. Specimens were also photographed at each time point.
A digital analytical scale accurate to 0.001 g was used. A Petri dish was placed on the scale and the balance zeroed. For each sample of mucin at each time point, the mucin was transferred from the test tube using forceps to this Petri dish. Only mucin that was solid enough to be transferred with forceps was measured.
Data analysis
Descriptive statistics including mean and standard deviation were performed for solutions that were tested over at least three of the five trials. Given the non-normal distribution of the data, the independent samples Kruskal–Wallis test and pairwise comparisons of solutions was used to determine statistical significance. Trial 1 was excluded from these calculations due to the missing data. The p-value was set at 0.05.
Results
Overall, after 24-h of treatment, BromAc ® , NAC and bromelain showed superior effects when combined with collagenase compared to BromAc ® , NAC and bromelain alone. BromAc ® , as well as the combination of BromAc ® with collagenase, demonstrated the fastest rates of degradation of hard mucin compared to all other combinations. BromAc ® with collagenase found to be most effective treatment as observed at 3- and 5-h post-treatment (Figure 1). These findings, however, were not statistically significant (Table 7, Appendix 2).

Average weight in hard mucin specimens over 0, 1, 3, 5 and 24 h when submersed in BromAc, BromAc + collagenase, NAC + collagenase, bromelain + collagenase and collagenase alone.
Appendix 1 outlines the results from all five trials, and Appendix 2 outlines the descriptive statistics carried out for the solutions that were tested in at least three trials. A wide range in standard deviation was noted across these data up to 57.2. The large standard deviation values suggest variability in the results and are likely due to the differing of solutions tested in each trial.
The quality of dissolution also differed between solutions. Figure 2 demonstrates a sample of hard mucin that has been completely dissolved by BromAc ® , NAC and bromelain in combination with collagenase, as well as collagenase alone, at 24 h. NAC with collagenase, bromelain with collagenase and collagenase alone all showed a progressively more gelatinous residual solution compared with the combination of BromAc ® with collagenase.

Quality of hard mucin dissolution in BromAc, bromelain and NAC with collagenase 250 μg/mL and collagenase 250 μg/mL control after 24 h. A: BromAc + collagenase 250. B: Bromelain + collagenase 250. C: NAC + collagenase 250. D: Collagenase 250.
Effect of BromAc ® with varying concentrations of collagenase
Figure 3 demonstrates a qualitative display of BromAc ® with collagenase at 250 μg/mL at each time point assessed.
Qualitative demonstration of dissolution of hard mucin when submersed in BromAc ® + collagenase 250 ug/mL, trial 2. A: 0 h, B: 1 h, C: 3 h, D: 5 h, E: 24 h.
BromAc ® and collagenase demonstrated a dose–response relationship consistently across all trials with 100 % dissolution of the hard mucin after 24-h of treatment. Of all the solutions tested, only BromAc ® with collagenase consistently demonstrated a superior hard mucin dissolution effect compared to BromAc ® alone with an average of 96 % dissolution of hard mucin compared to 70 % at 24 h. Figure 4 outlines the average weights of hard mucin samples for BromAc ® with each concentration of collagenase tested at each time point. BromAc ® with collagenase at concentrations of 62.5, 125 and 250 μg/mL all demonstrated greater dissolution of mucin to BromAc ® alone at 24 h. However, when compared to BromAc ® alone, only BromAc ® and collagenase at 250 μg/mL consistently demonstrated superior effects at 3 and 5 h with an average of 59 % dissolution at 3 h and 76 % dissolution at 5 h compared to 50 % dissolution at 3 h and 61 % dissolution at 5 h for BromAc ® alone.

Average weight in hard mucin specimens over 0, 1, 3, 5 and 24 h when submersed in BromAc ® + collagenase at varying concentrations as well as BromAc ® and collagenase alone.
Collagenase alone demonstrated hydrational effect at 1 h post-treatment followed by a steady degradation rate to almost 100 % dissolution by 24 h of treatment.
Additional solutions
The effect of NAC when combined with collagenase
While up to 100 % effective at 24 h, when compared to BromAc ® alone, NAC with collagenase was less effective at each earlier time point (Figure 5). The superior effect at 24 h was therefore attributed to the collagenase component.

Average weight in hard mucin specimens over 0, 1, 3, 5 and 24 h when submersed in NAC + collagenase at varying concentrations as well as BromAc, NAC and collagenase alone.
The effect of bromelain when combined with collagenase
Bromelain with collagenase was demonstrated to be less effective than BromAc ® alone and BromAc ® with collagenase. Its effect was similar to collagenase alone indicating that bromelain by itself is minimally effective in dissolving hard mucin [Figure 6].

Average weight in hard mucin specimens over 0, 1, 3, 5 and 24 h when submersed in bromelain + collagenase at varying concentrations as well as BromAc, bromelain and collagenase alone.
The effect of bromelain/BromAc ® when combined with cysteamine
Bromelain with cysteamine demonstrated 52 % dissolution of hard mucin by 5 h with its effect plateauing to 60 % at 24 h. In trial 2, when bromelain and cysteamine were combined with collagenase, dissolution of hard mucin was enhanced up to 85 % at 24 h; however, it should be noted that this combination used a concentration of collagenase that was twice the current proven safe concentration. Given the combinations with cysteamine were overall found to be less effective than BromAc ® alone in the first two trials, it was hence excluded from ongoing trials [Figure 7].

Average weight in hard mucin specimens over 0, 1, 3, 5 and 24 h when submersed in bromelain + cysteamine, bromelain + cysteamine + collagenase, and BromAc ® and cysteamine alone.
Discussion
In this study, BromAc ® with collagenase was the only combination that resulted in faster mucin degradation when compared to BromAc ® alone as well as all other tested solutions. The tumour stroma, composed largely of collagen, plays a key role in chemoresistance in hard tumours [7]. It is therefore hypothesised that intraperitoneal administration of collagenase facilitates break down of the tumour stroma, allowing enhanced penetration of other intraperitoneal therapies such as BromAc®.
Hard mucin treated with collagenase alone, as well as collagenase combined with bromelain, NAC and BromAc® consistently demonstrated an increase in weight at 1 h followed by a linear decrease down to negligible quantities by 24 h. The increase in weight after 1 h was thought to be hydrational with the breakdown of the tumour stroma, resulting in the hard mucin absorbing water from the solution.
Given the abundance of collagen within the human body, there is a real safety concern regarding the effect of collagenase when administered into the abdomen, with complications such as catastrophic bleeding and gastrointestinal perforation known to occur in high doses [7], 12], 13]. Collagenase at a concentration of 250 μg/mL has already been demonstrated to be safe and effective in both rat and pig model studies. However, these studies have assessed its use over a relatively short timeframe [7], 12], 13].
BromAc ® is currently used in the non-operative setting with the dose administered via a percutaneous drain and left inside the abdomen for 24 h before aspirating and repeating the dose [5]. The question remains whether leaving BromAc ® and collagenase – in any concentration – is safe at 24 h or whether further studies should focus on BromAc ® and collagenase within a shorter timeframe, such as in the setting of HIPEC. A preclinical study has already demonstrated the addition of BromAc ® to HIPEC to be safe; thus, this line of research would also be feasible to pursue [14].
While BromAc® with concentrations of 62.5–250 μg/mL of collagenase demonstrated superior results at 24 h compared to BromAc® alone, only BromAc® with collagenase 250 μg/mL demonstrated superior results at hours 3 and 5. This is clinically relevant as the synergistic effect of the two agents may shorten the exposure time of the proposed therapy and therefore limit potential toxic effects.
Hard mucin treated with cysteamine also demonstrated an increase in weight 1 h post-treatment which was presumed to be hydrational. By 24 h of treatment, the residual hard mucin quantities were very similar between cysteamine and bromelain with cysteamine. Bromelain with cysteamine was, however, consistently less effective than BromAc® alone, suggesting less of a synergistic effect between bromelain and cysteamine compared with bromelain and NAC. Given the vastly inferior results with cysteamine in the first two trials, it was excluded from the remaining three trials to allow further concentrations of collagenase to be assessed.
This study was mostly limited by the relatively small number of trials as well as the variation in solutions tested in each trial. This reduced the reliability of the findings and hence compromised the ability to perform meaningful statistical analyses. While these findings did not demonstrate statistical significance, qualitatively there was a clear superior dissolution effect of BromAc® with collagenase compared to BromAc® alone. Alternative quantitative methods in addition to, or instead of, measuring weight difference alone should be considered for future studies. Rheology is the study of how materials deform and flow in response to applied forces [15]. Rheomuco is a rheometer designed specifically to examine the elastic, viscous and plastic properties of mucus [16]. Future studies could consider the use of Rheomuco to assess the properties of the hard mucin at each time point. While BromAc® with collagenase may not result in 100 % dissolution of hard mucin, it may be that its effect reduces the mucin viscosity enough that it is able to be drained out.
This study also was carried out using hard mucin collected from a single patient. Future studies should include hard mucin collected from various patients to ensure that the findings are reliable and repeatable.
Another consideration is the effect that freezing the human hard mucin sample has had on its structural integrity. During the freezing process, ice forms in both intra and extracellular spaces, and it is understood that this damages the extracellular matrix structure; however, its subsequent impact on the post-thaw extracellular matrix structure integrity is incompletely understood [17]. Given it is hypothesised that the superior effect of BromAc® with collagenase is secondary to the effect collagenase has on the extracellular matrix, it would be important to establish the exact effects of freezing and thawing mucin. Future studies should consider testing with fresh mucin samples or considering embedding mucin samples in cryoprotectant media before freezing, which has been demonstrated to preserve the mucin structure [18].
Furthermore, commercially, collagenase can be produced by various methods, most commonly by fermentation of Clostridium histolyticum due to the relative ease and lower cost of production [8]. There are six main types of collagenases, with each type having its maximum effect on different tissue types [8]. There is considerable variability in the types and combinations of collagenase used in current studies [7], 12], 13]. This study used type IV collagenase that was already available in the research lab. Whether a different type of collagenase or a combination of collagenases is most effective should be examined in future studies.
A final point of consideration is the pharmaceutical stability of BromAc® with collagenase. This was not assessed during this study, however, would be relevant when considering its potential clinical uses and should be the focus of further studies.
Conclusions
For patients with inoperable PMP, or who are otherwise not operative candidates, there is a current lack of effective treatments for the symptomatic management of hard mucin. This in vitro study using a human sample of hard mucin demonstrates the potential efficacy of combining collagenase with BromAc ® for this purpose; however, statistical analysis was limited due to the number and consistency of its trials. Future in vitro studies with a variety of hard mucin samples should be carried out to confirm efficacy, followed by in vivo studies with animal models to establish treatment safety.
Funding source: MucPharm
-
Research ethics: The study was conducted with pre-existing approval from the St George Hospital Ethics Committee (approval number 2023/ETH01237).
-
Informed consent: Not applicable.
-
Author contributions: All authors have accepted responsibility for the entire content of this manuscript and approved its submission.
-
Use of Large Language Models, AI and Machine Learning Tools: None declared.
-
Conflict of interest: Co-authors Mathew Eapen and Pooja Narang are employed by Mucpharm Pty Ltd., Australia, and Professor David Morris is a co-founder of MucPharm Pty Ltd., Australia. MucPharm Pty Ltd., owns the patent for BromAc®.
-
Research funding: This study has been partially funded by Mucpharm Pty Ltd., Australia.
-
Data availability: The authors confirm that the data supporting the findings of this study are available within the article and its supplementary materials.
References
1. Pillai, K, Akhter, J, Mekkawy, A, Chua, TC, Morris, DL. Physical and chemical characteristics of mucin secreted by pseudomyxoma peritonei (PMP). Int J Med Sci 2017;14:18–28. https://doi.org/10.7150/ijms.16422.Suche in Google Scholar PubMed PubMed Central
2. Yang, J, Glenn, D, Lodh, S, Valle, S, Morris, DL. Long-term treatment of unresectable pseudomyxoma peritonei with multiple treatments of intratumoural bromelain and acetylcysteine (BromAc(®)): a case report. Case Rep Oncol 2023;16:1551–6. https://doi.org/10.1159/000534202.Suche in Google Scholar PubMed PubMed Central
3. Lin, Y-L, Xu, D-Z, Li, X-B, Yan, F-C, Xu, H-B, Peng, Z, et al.. Consensuses and controversies on pseudomyxoma peritonei: a review of the published consensus statements and guidelines. Orphanet J Rare Dis 2021;16:85. https://doi.org/10.1186/s13023-021-01723-6.Suche in Google Scholar PubMed PubMed Central
4. Villarejo-Campos, P, García-Arranz, M, Qian, S, Jiménez de Los Galanes, S, Domínguez-Prieto, V, Vélez-Pinto, JF, et al.. Under the hood: understanding the features of mucin in pseudomyxoma peritonei. J Clin Med 2023;12:4007. https://doi.org/10.3390/jcm12124007.Suche in Google Scholar PubMed PubMed Central
5. Valle, SJ, Akhter, J, Mekkawy, AH, Lodh, S, Pillai, K, Badar, S, et al.. A novel treatment of bromelain and acetylcysteine (BromAc) in patients with peritoneal mucinous tumours: a phase I first in man study. Eur J Surg Oncol 2021;47:115–22. https://doi.org/10.1016/j.ejso.2019.10.033.Suche in Google Scholar PubMed
6. Wen, HK, Valle, SJ, Morris, DL. Bromelain and acetylcysteine (BromAc(®)): a novel approach to the treatment of mucinous tumours. Am J Cancer Res 2023;13:1522–32.Suche in Google Scholar
7. García-Olmo, D, Villarejo Campos, P, Barambio, J, Gomez-Heras, SG, Vega-Clemente, L, Olmedillas-Lopez, S, et al.. Intraperitoneal collagenase as a novel therapeutic approach in an experimental model of colorectal peritoneal carcinomatosis. Sci Rep 2021;11:503. https://doi.org/10.1038/s41598-020-79721-0.Suche in Google Scholar PubMed PubMed Central
8. Wang, ZZ, Wang, K, Xu, LF, Su, C, Gong, JS, Shi, JS, et al.. Unlocking the potential of collagenases: structures, functions, and emerging therapeutic horizons. Biodes Res 2024;6:0050. https://doi.org/10.34133/bdr.0050.Suche in Google Scholar PubMed PubMed Central
9. Dias, J, Tharmanathan, P, Arundel, C, Welch, C, Wu, Q, Leighton, P, et al.. Collagenase injection versus limited fasciectomy for Dupuytren’s contracture. N Engl J Med 2024;391:1499–510. https://doi.org/10.1056/nejmoa2312631.Suche in Google Scholar
10. Patry, J, Blanchette, V. Enzymatic debridement with collagenase in wounds and ulcers: a systematic review and meta-analysis. Int Wound J 2017;14:1055–65. https://doi.org/10.1111/iwj.12760.Suche in Google Scholar PubMed PubMed Central
11. Gallego-Villar, L, Hannibal, L, Häberle, J, Thöny, B, Ben-Omran, T, Nasrallah, GK, et al.. Cysteamine revisited: repair of arginine to cysteine mutations. J Inherit Metab Dis 2017;40:555–67. https://doi.org/10.1007/s10545-017-0060-4.Suche in Google Scholar PubMed PubMed Central
12. Barambio, J, García-Arranz, M, Villarejo Campos, P, Vélez Pinto, JF, Clemente, LV, Gómez-Heras, SG, et al.. Chemical scalpel: an experimental collagenase-based treatment for peritoneal adhesions. Biology 2022;11:1159. https://doi.org/10.3390/biology11081159.Suche in Google Scholar PubMed PubMed Central
13. Garcia-Arranz, M, Villarejo-Campos, P, Barambio, J, Garcia Gomez-Heras, S, Vega-Clemente, L, Guadalajara, H, et al.. Toxicity study in a pig model of intraperitoneal collagenase as an “enzymatic scalpel” directed to break stroma in order to generate a new perspective for peritoneal carcinomatosis approach: an experimental research. World J Surg Oncol 2022;20:53. https://doi.org/10.1186/s12957-022-02524-2.Suche in Google Scholar PubMed PubMed Central
14. Mekkawy, AH, Breakeit, M, Rahman, MK, Pillai, K, Solanki, A, Octavia, F, et al.. Safety of BromAc(®) with Mitomycin C during hyperthermic intraperitoneal chemotherapy (HIPEC): a preclinical study. Am J Cancer Res 2025;15:1213–23. https://doi.org/10.62347/hqjh9945.Suche in Google Scholar PubMed PubMed Central
15. Janmey, PA, Schliwa, M. Rheology. Curr Biol 2008;18:R639–r41. https://doi.org/10.1016/j.cub.2008.05.001.Suche in Google Scholar PubMed PubMed Central
16. Wykoff, JA, Shaffer, KM, Araba, KC, Markovetz, MR, Patarin, J, de Saint Vincent, MV, et al.. Rapid viscoelastic characterization of airway mucus using a benchtop rheometer. J Vis Exp 2022;182:e63876. https://doi.org/10.3791/63876.Suche in Google Scholar PubMed PubMed Central
17. Teo, KY, DeHoyos, TO, Dutton, JC, Grinnell, F, Han, B. Effects of freezing-induced cell-fluid-matrix interactions on the cells and extracellular matrix of engineered tissues. Biomaterials 2011;32:5380–90. https://doi.org/10.1016/j.biomaterials.2011.04.008.Suche in Google Scholar PubMed PubMed Central
18. Cohen, M, Varki, N, Jankowski, M, Gagneux, P. Using unfixed, frozen tissues to study natural mucin distribution. J Vis Exp 2012;67:e3928. https://doi.org/10.3791/3928.Suche in Google Scholar PubMed PubMed Central
Supplementary Material
This article contains supplementary material (https://doi.org/10.1515/pp-2025-0026).
© 2025 the author(s), published by De Gruyter, Berlin/Boston
This work is licensed under the Creative Commons Attribution 4.0 International License.
Artikel in diesem Heft
- Frontmatter
- Review Article
- Advancements in nebulizers for pressurized intraperitoneal aerosol chemotherapy (PIPAC)
- Research Articles
- Assessing data completeness in the international society for the study of pleura and peritoneum (ISSPP) PIPAC database: a multicenter evaluation from 2020–2024
- Comparison of clinical characteristics and outcomes between patients with complicated pleural infection caused by Streptococcus anginosus group and Klebsiella pneumoniae
- Co-occurrence of peritoneal mesothelioma and genitourinary cancers: a case series with comparative outcomes
- The addition of collagenase to BromAc ® for the management of inoperable pseudomyxoma peritonei – in vitro results
- Letter to the Editor
- Adhesion obstacles effect on PIPAC patients with primary unresectable or recurrent platinum-resistant peritoneal metastasis from ovarian cancer
Artikel in diesem Heft
- Frontmatter
- Review Article
- Advancements in nebulizers for pressurized intraperitoneal aerosol chemotherapy (PIPAC)
- Research Articles
- Assessing data completeness in the international society for the study of pleura and peritoneum (ISSPP) PIPAC database: a multicenter evaluation from 2020–2024
- Comparison of clinical characteristics and outcomes between patients with complicated pleural infection caused by Streptococcus anginosus group and Klebsiella pneumoniae
- Co-occurrence of peritoneal mesothelioma and genitourinary cancers: a case series with comparative outcomes
- The addition of collagenase to BromAc ® for the management of inoperable pseudomyxoma peritonei – in vitro results
- Letter to the Editor
- Adhesion obstacles effect on PIPAC patients with primary unresectable or recurrent platinum-resistant peritoneal metastasis from ovarian cancer